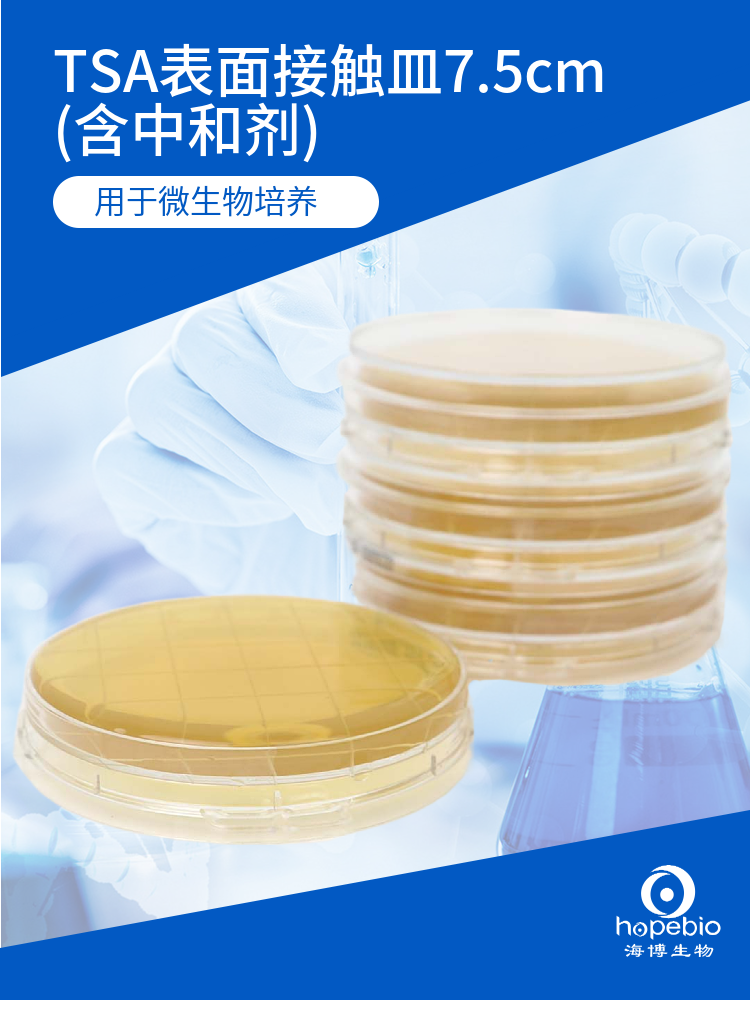
TSA表面接触皿7.5cm（含中和剂）
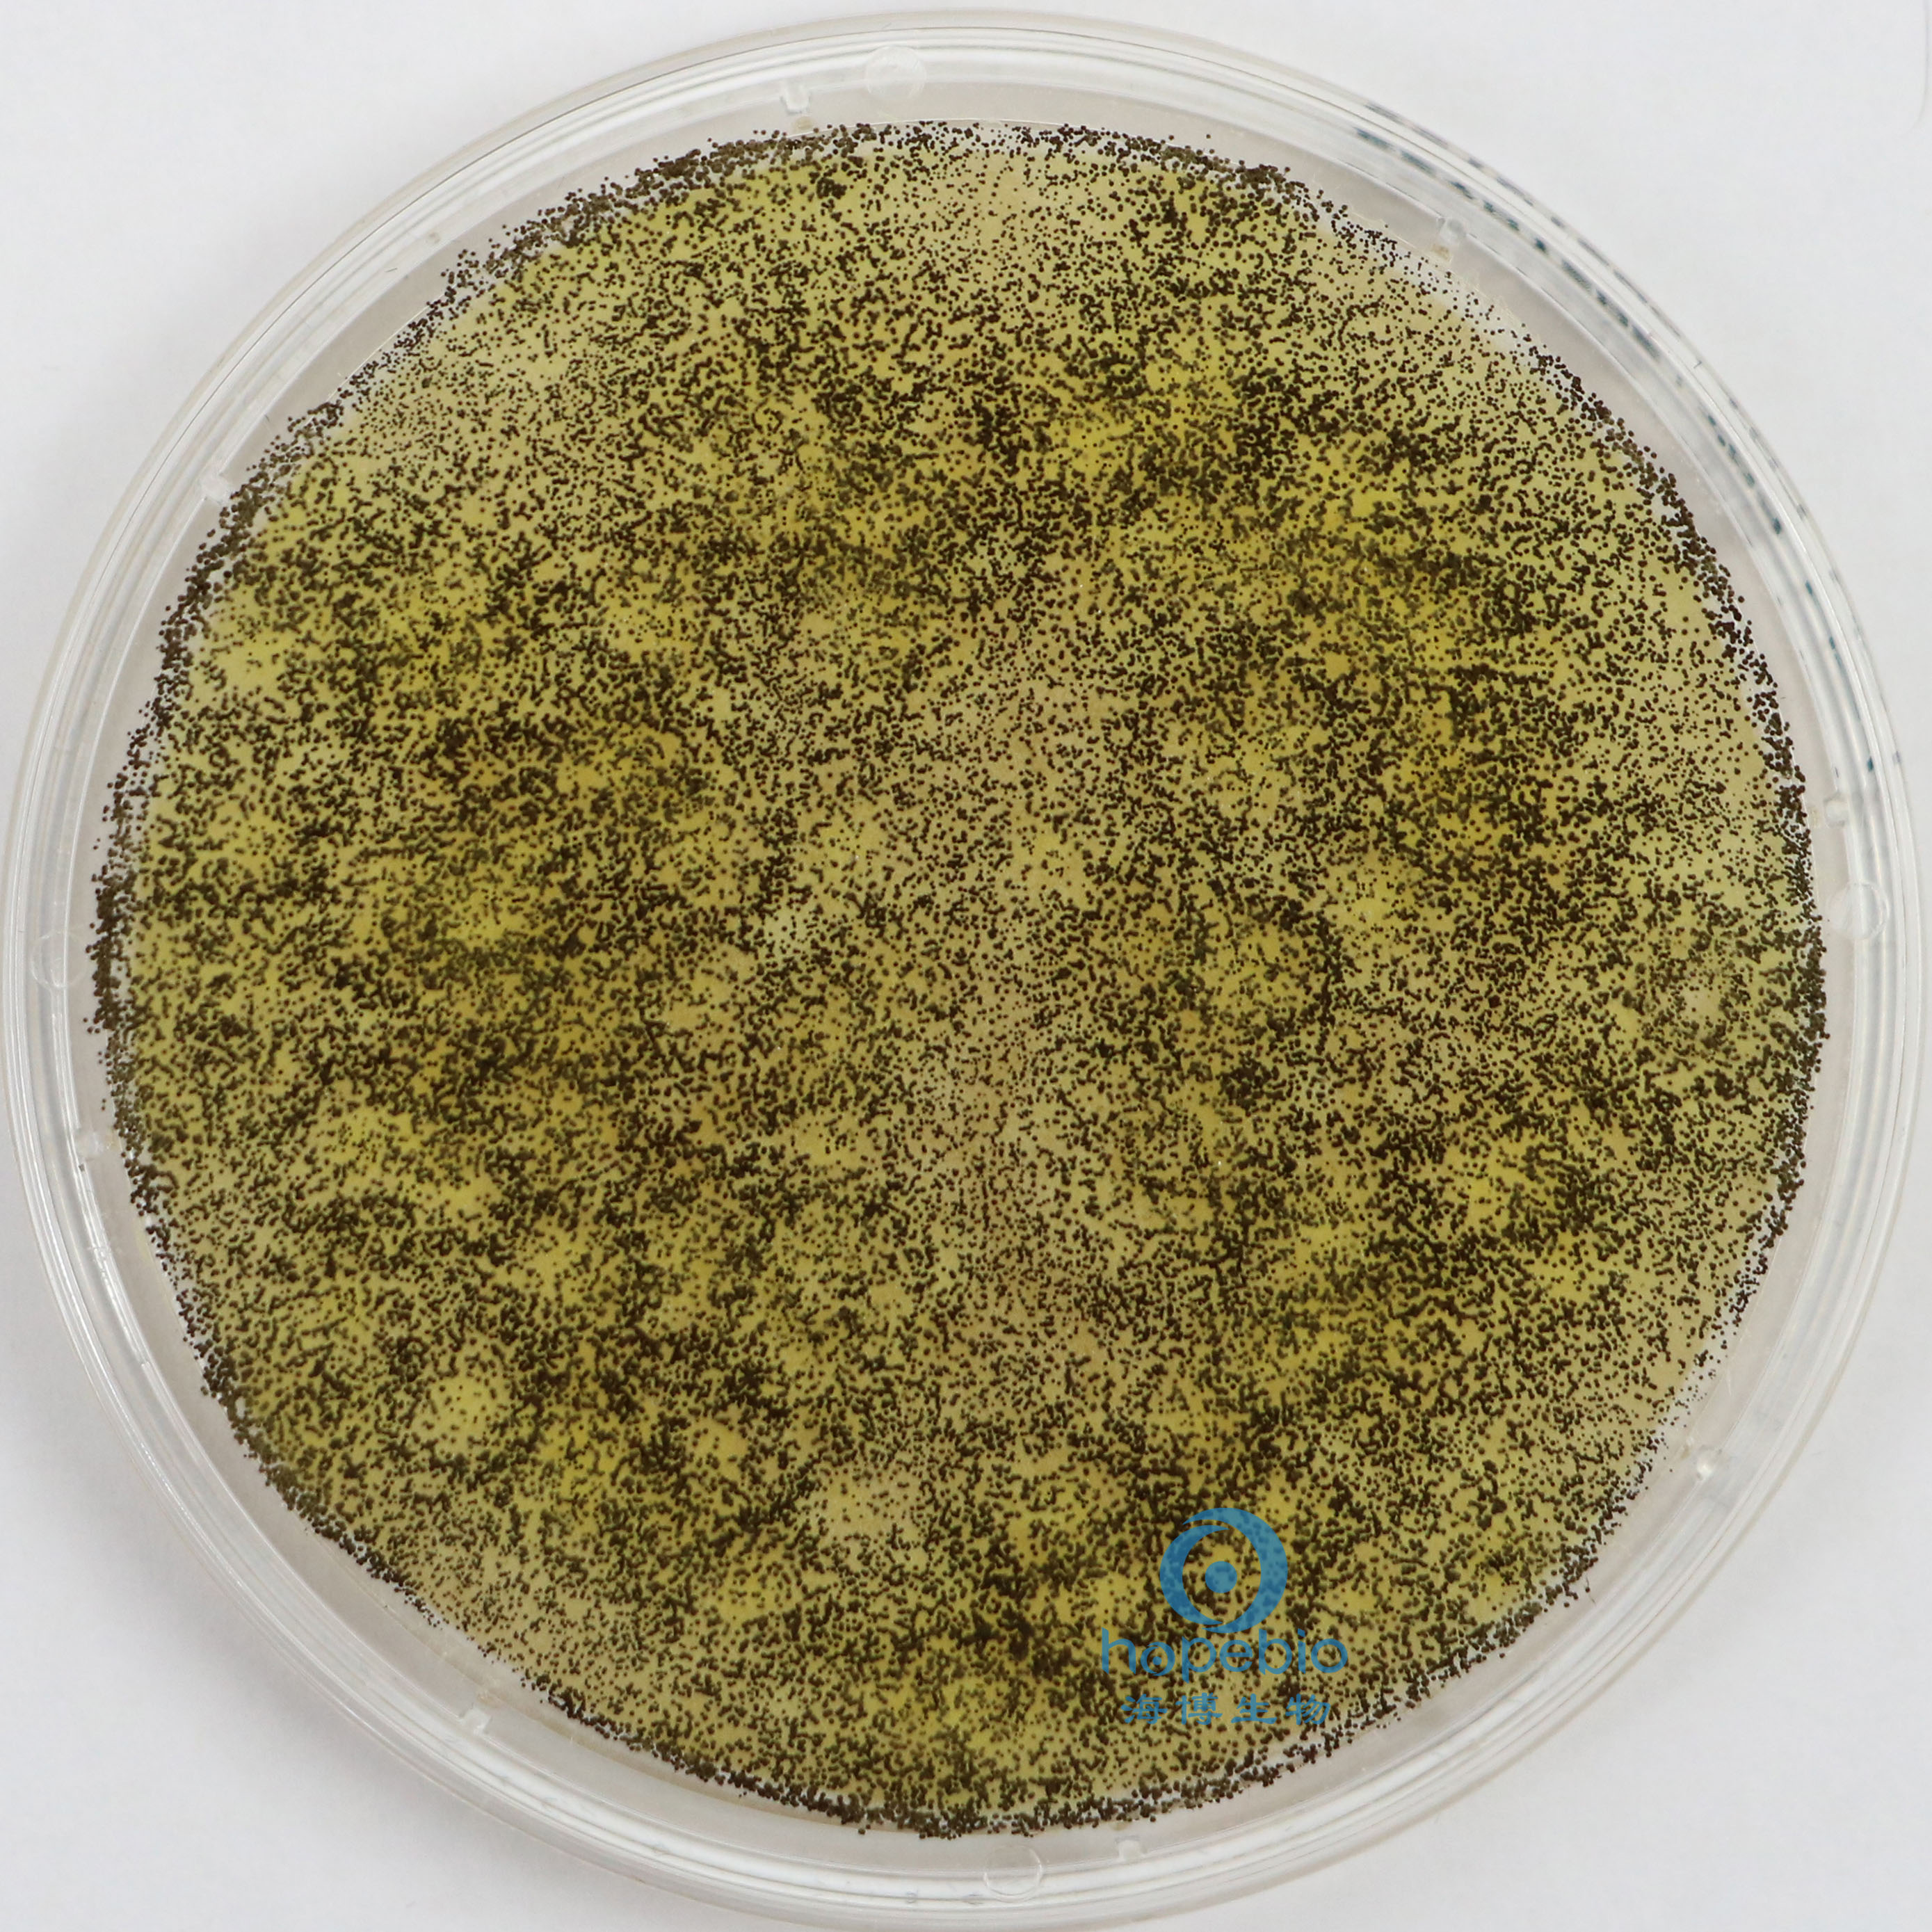
TSA表面接触皿7.5cm（含中和剂）

相关产品推荐更多 >
万千商家帮你免费找货
0 人在求购买到急需产品
- 详细信息
- 技术资料
- 库存:
999
- 英文名:
TSA surface contact dish
- 保质期:
六个月
- 供应商:
青岛海博生物
- 保存条件:
/
- 规格:
10个/包

用途:用于微生物培养
检验原理:胰酪胨(酪蛋白胰酶水解物)、大豆木瓜蛋白酶水解物提供氮源、维生素和生长因子;氯化钠维持均衡的渗透压;琼脂是培养基的凝固剂。
不同细菌在TSA表面接触皿生长特征:
|
|
|
|
| jiin黄色葡萄球菌 有黄色色素 |
|
大肠杆菌 无色透明大菌落 |
|
|
|
|
| 伤han沙门氏菌 无色大菌落 |
|
枯草芽孢杆菌 白色不规则菌落 |
|
|
|
|
| 铜绿假单胞菌 有绿色色素 |
|
白色念珠菌 白色菌落 |
| |
|
|
|
|
| 黑曲霉 有黑色孢子 |
TSA表面接触皿7.5cm(2-25℃)(含中和剂)微生物灵敏度试验:
接种以下质控菌株,放置30-35℃需氧培养18-24小时。
注:回收率计算时,用TSA琼脂做对照培养基。

风险提示:丁香通仅作为第三方平台,为商家信息发布提供平台空间。用户咨询产品时请注意保护个人信息及财产安全,合理判断,谨慎选购商品,商家和用户对交易行为负责。对于医疗器械类产品,请先查证核实企业经营资质和医疗器械产品注册证情况。
技术资料暂无技术资料 索取技术资料
TSA表面接触皿7.5cm(含中和剂)
¥60